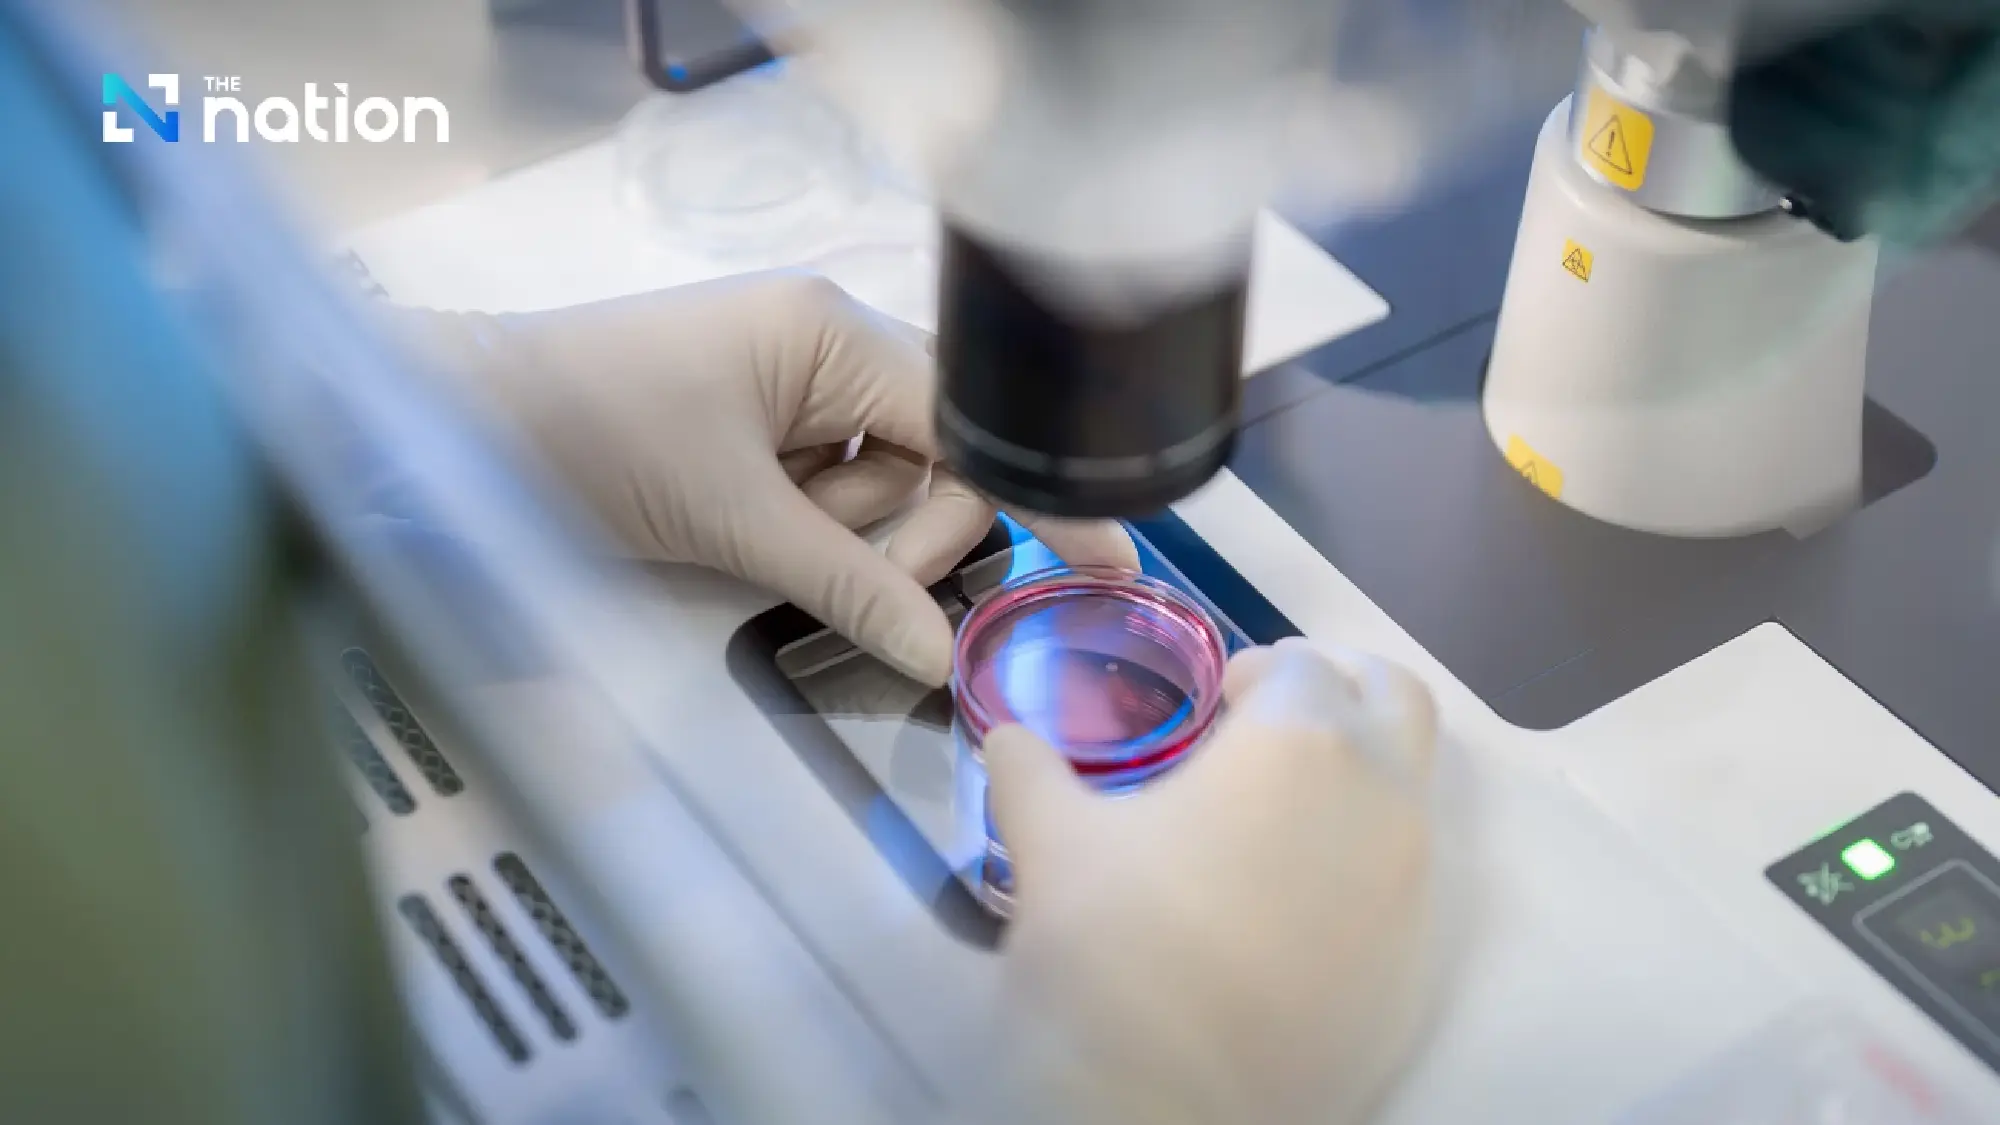
Gift Fertility and PRINC Group Sign Strategic Partnership

Advancing Total Fertility Solution through an Integrated Fertility Network
March 2, 2026 – Samut Prakan, Thailand – Gift Fertility, a leading reproductive medicine provider in Thailand, announced the signing of a Memorandum of Understanding (MOU) with PRINC Group to establish a long-term strategic partnership aimed at strengthening and advancing reproductive healthcare through a more integrated, scalable, and sustainable service model.

This collaboration represents more than an expansion of medical services. It marks a significant step toward realizing the shared vision of “Advancing Total Fertility Solution.” Under this strategic framework, both organizations plan to develop an Integrated Fertility Network as the operational model to systematically connect dedicated fertility centers with PRINC’s hospital network.
The partnership includes the establishment of a Joint Venture Company to develop and operate specialized Fertility Centers, while expanding access points through Satellite Clinics within selected hospitals under the PRINC network. This structure is designed to enhance referral efficiency, improve continuity of care, and strengthen overall service standards.

Mr. Lionel Soh Wee Chua, Chairman of the Board of Gift Fertility Co., Ltd., stated “This partnership reflects our long-term perspective on the future of reproductive medicine in Thailand. The next stage of industry progress is not defined solely by technological competition, but by building a professionally managed, well-governed healthcare system that can deliver high standards consistently and scale sustainably.
Fertility care should not be constrained by fragmented structures. It must be designed as an integrated network with clear governance, strong clinical accountability, and patient-centered outcomes at its core.
By combining Gift Fertility’s specialized expertise with PRINC’s hospital network strength, we are establishing a new infrastructure for fertility services — one that strengthens clinical outcomes while creating long-term value for the broader healthcare ecosystem.”
From Technology to System-Level Confidence
Gift Fertility believes that success in Assisted Reproductive Technology (ART) is not determined by equipment alone, but by a carefully designed system built upon four essential pillars: evidence-based innovation, expert professionals, high laboratory standards, and rigorous governance.
While advanced technologies are adopted to enhance precision in clinical decision-making, equal emphasis is placed on process stability, standardized protocols, and continuous outcome monitoring at the organizational level.
As Mr. Lionel further emphasized “Technology enhances precision. However, sustainable confidence arises from systems that are standardized, transparent, and accountable.”
At the Board level, clinical outcomes — including fertilization rates, embryo quality, and post-transfer results — are reviewed regularly to ensure continuous evaluation and improvement of treatment processes.

Total Fertility Solution: Designing a Connected Care Model
The partnership aligns directly with Gift Fertility’s vision of a Total Fertility Solution — an integrated approach that encompasses preventive, curative, and wellness dimensions of reproductive health. Through the Integrated Fertility Network model, early-stage consultation, treatment, and advanced diagnostics can be seamlessly connected within a coordinated structure. This enhances care continuity, optimizes referral pathways, and elevates service standards across the network.

Laying the Foundation for Regional Fertility Leadership
This collaboration reflects a broader shift within Thailand’s healthcare industry toward developing professionally managed specialty networks capable of serving both domestic and international patients.
Dr. Wityavate Rakkulchon, M.D., and Mr. Kanut Sirisuwat, Co-CEOs of Principal Capital Public Company Limited, stated “This collaboration with Gift Fertility represents an important step in strengthening the capabilities of our hospital network in response to the growing demand for fertility services. By combining our hospital infrastructure with Gift Fertility’s specialized expertise, we aim to enhance accessibility to high-quality fertility care delivered under consistent standards.”
By integrating clinical specialization with network-scale infrastructure, the partnership represents a meaningful step toward creating long-term value for patients, healthcare professionals, and Thailand’s healthcare system as a whole.

